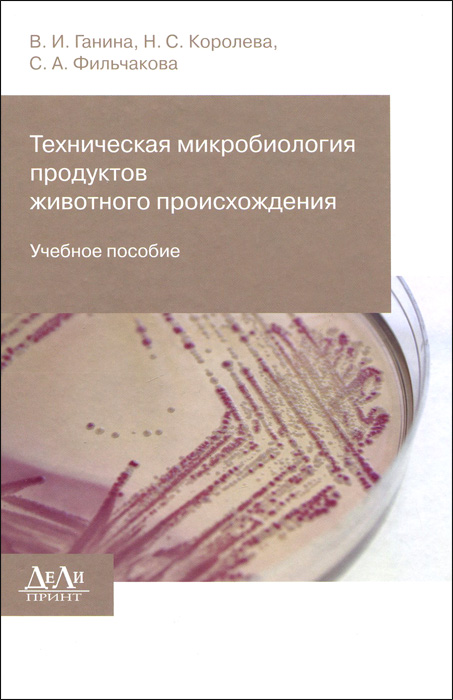

Техническая микробиология продуктов животного происхождения. Учебное пособие В. И. Ганина, С. А. Фильчакова, Н. С. Королева (книга)
Подробная информация о книге «Техническая микробиология продуктов животного происхождения. Учебное пособие В. И. Ганина, С. А. Фильчакова, Н. С. Королева». Сайт не предоставляет возможности читать онлайн или скачать бесплатно книгу «Техническая микробиология продуктов животного происхождения. Учебное пособие В. И. Ганина, С. А. Фильчакова, Н. С. Королева».
Поделиться
Рейтинг книги enc.su: 0,0
О книге
В учебном пособии рассмотрены: история развития отечественной технической микробиологии; виды технической микрофлоры сырья и продуктов из мяса, молока, рыбы и гидробионтов; методы микробиологического контроля продуктов, производимых из животного сырья; вопросы микробиологического и санитарно-гигиенического контроля производства продуктов животного происхождения на предприятиях.
Учебное пособие предназначено для студентов вузов, аспирантов и практикующих специалистов. Это и многое другое вы найдете в книге Техническая микробиология продуктов животного происхождения. Учебное пособие (В. И. Ганина, Н. С. Королева, С. А. Фильчакова)
| Полное название книги | В. И. Ганина, С. А. Фильчакова, Н. С. Королева Техническая микробиология продуктов животного происхождения. Учебное пособие |
| Тип | Книга |
| Авторы | В. И. Ганина, С. А. Фильчакова, Н. С. Королева |
| Категории | Для техникумов и вузов, Образование и наука, Книги |
| ISBN | 9785943431715 |
| Возрастное ограничение | 18 |
| Издательство | ДеЛи принт |
| Год | 2014 |
| Название транслитом | tehnicheskaya-mikrobiologiya-produktov-zhivotnogo-proishozhdeniya-uchebnoe-posobie-v-i-ganina-n-s-koroleva-s-a-filchakova |
| Просмотров | 8 |
| Рейтинг enc.su | 0,0 |
Напишите вашу рецензию на книгу:
В. И. Ганина, С. А. Фильчакова, Н. С. Королева «Техническая микробиология продуктов животного происхождения. Учебное пособие»
Рецензии пользователей
Пока еще никто не написал рецензию на эту книгу.
